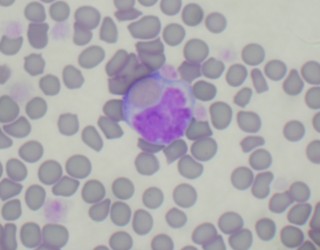
picture-1

A 10 year-old male neutered DSH was presented with a recent history of lethargy, anorexia and enlarged spleen on abdominal palpation.
The cat was slightly depressed but responsive. The physical examination revealed pale and slightly jaundice mucous membranes, tachycardia (HR 180); an enlarged spleen was found on abdominal palpation, the rectal temperature was 38.0 C and the respiratory rate was 20/minutes.
The initial problem list included anaemia, jaundice and splenomegaly. The tachycardia was believed to be secondary to the presumptive anaemia, although a primary cardiac disease causing poor perfusion was not ruled out.
Haematology revealed moderate anaemia (PCV 14%, RBC 3,500,000 ul, Hgb 7.2 g/dl), non-regenerative (aggregate reticulocytes 39,000 ul) with microcytosis (40.7 fl) but increased RDW (23.4%).There was also neutropaenia (2100 ul) with other WBCs lines unaffected. The automatic platelets count was 306.000 ul, with adequate number in the blood smear. The evaluation of the blood smear revealed mild to moderate anisocytosis with some reactive lymphocytes. Biochemistry revealed moderate increased bilirubin (40 umol/l). Electrolytes were unremarkable. Urine analysis with a sample collected by cystocentesis revealed USG 1065, 3+bilirubin, 2+haemoglobin and 1+protein. The urine sediment revealed RBC 0-1/HPF.
An ELISA test for antigens FeLV was negative and an ELISA test for antibodies FIV was also negative. An agglutination test on saline (dilution 1:2) gave a negative result. A coagulation profile revealed PT, aPTT and D-dimer within normal range.
Coombs test were negative for polyvalent reagents, IgM, IgG at both 4 C° and 37 C°.
PCR from a blood sample for 3 species Haemoplasma (H.felis, H.haemominutum and H.turincensis) was negative. Thoracic radiographs did not reveal any major abnormalities. Abdominal ultrasound showed mildly enlarged and hyperecchoic liver, enlarged spleen with irregular margins, no other abnormalities were found.
The cat received 10 ml/kg IV Oxygloblin , shortly afterward a bone-marrow aspirate and biopsy and FNA of the spleen and liver under general anaesthesia were performed.
Cytology of the spleen was diagnostic of extramedullary haematopoiesis. Cytology of the liver was diagnostic of extramedullary haematopoiesis with sign of erytrophagia (picture 1). Bone marrow cytology was marked erythroid hyperplasia (picture 2). PCR FeLV from the bone sample marrow was negative.
The final diagnosis was non-regenerative immune-mediated haemolytic anaemia.
The cat after the blood transfusion was started on prednisolone and doxycyline pending the Haemoplasma panel.
Clinically the cat improved rapidly after oxyglobin, haemoglobin after 24 hours was 8.7 g/dl. The cat restarted eating at day 2 of hospitalisation . The PCV was 24% at day 3 of hospitalisation. At day 4 of hospitalisation haematology revealed regenerative anaemia (PCV 28%, aggregate reticulocytes 700000 ul) the neutropaenia resolved (3600 ul) as well as the thrombocytopaenia (620000 ul). The evaluation of the blood smear revealed 2+ anisocytosis and adequate platelets.
The cat was discharged on prednisolone and 7 days course of doxycycline. The dose of prednisolone was decreased of 25% after 40 days as the PCV was stable and cat clinically well. The prednisolone was gradually decreased and stopped over 2 months time with periodic PCV checked. The cat had a complete recovery after 14 weeks.
Non-regenerative immune-mediated haemolytic anaemia is a variant of immune mediated haemolytic anaemia in which the autoantibodies are mainly against the reticulocytes rather than against mature RBCs. This gives the classical finding of haemolysis such as anaemia, bilirubinaemia, bilirubinuria without sign of regeneration (low reticulocytes count). Negative Coombs test is not uncommon.
Lack of spherocytes in the blood smear is also not uncommon. Furthermore in feline medicine due to the physiologic anisocytosis and lack of central pallor in RBCs, the detection of spherocytes in the blood smear can be very challenging if not impossible.
Concurrent neutropaenia and thrombocytopaenia, usually mild, have been reported mainly with the non regenerative IMHA due to the bone marrow involvement.
The finding of enlarged spleen and liver due to the extramedullary haematopoiesis and erytrophagia are not unusual.
For the diagnosis it is important to rule out a primary disease able to cause the immune mediated haemolysis. Infectious diseases and neoplasia are the most common causes. In particular haemolymphatic malignancies such as lymphoma and leukaemia (FeLV dependant or not) need to be considered first. In this contest cytology and or biopsy of abnormal organs and possibly of the bone marrow are very useful.
The prognosis is generally better compared to dogs in which apparently thromboembolic complications of IMHA are much more common.
Furthermore thromboembolic events tend to rarer with the non-regenerative forms of IMHA compared to the classical one.
Most of the cats respond to glucorticosteroids alone; cyclosporine, human immunoglobulin and mophetil mycophenolate have been described as second line agents for immune mediated haematological diseases in cats.